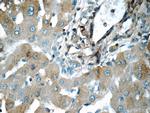
CHCHD3 Antibody in Immunohistochemistry (Paraffin) (IHC (P))

Search
Proteintech
CHCHD3 Polyclonal Antibody
{{$productOrderCtrl.translations['antibody.pdp.commerceCard.promotion.promotions']}}
{{$productOrderCtrl.translations['antibody.pdp.commerceCard.promotion.viewpromo']}}
{{$productOrderCtrl.translations['antibody.pdp.commerceCard.promotion.promocode']}}: {{promo.promoCode}} {{promo.promoTitle}} {{promo.promoDescription}}. {{$productOrderCtrl.translations['antibody.pdp.commerceCard.promotion.learnmore']}}
产品信息
25625-1-AP
种属反应
已发表种属
宿主/亚型
分类
类型
抗原
偶联物
形式
浓度
规格
纯化类型
保存液
内含物
保存条件
运输条件
产品详细信息
Immunogen sequence: MGGTTSTRR VTFEADENEN ITVVKGIRLS ENVIDRMKES SPSGSKSQRY SGAYGASVSD EELKRRVAEE LALEQAKKES EDQKRLKQAK ELDRERAAAN EQLTRAILRE RICSEEERAK AKHLARQLEE KDRVLKKQDA FYKEQLARLE ERSSEFYRVT TEQYQKAAEE VEAKFKRYES HPVCADLQAK ILQCYRENTH QTLKCSALAT QYMHCVNHAK QSMLEKGG (1-227 aa encoded by BC014839)
靶标信息
Component of the MICOS complex, a large protein complex of the mitochondrial inner membrane that plays crucial roles in the maintenance of crista junctions, inner membrane architecture, and formation of contact sites to the outer membrane. Has also been shown to function as a transcription factor which binds to the BAG1 promoter and represses BAG1 transcription. Plays an important role in the maintenance of the MICOS complex stability and the mitochondrial cristae morphology.
仅用于科研。不用于诊断过程。未经明确授权不得转售。
生物信息学
蛋白别名: Coiled-coil-helix-coiled-coil-helix domain-containing protein 3; coiled-coil-helix-coiled-coil-helix domain-containing protein 3, mitochondrial; FLJ20420; MICOS complex subunit MIC19; mitochondrial contact site and cristae organizing system subunit 19; mitochondrial inner membrane organizing system 3; protein phosphatase 1, regulatory subunit 22; unnamed protein product
基因别名: 0610041L09Rik; 1700039J09Rik; AW558177; CHCHD3; MIC19; MICOS19; MINOS3; PPP1R22
UniProt ID: (Human) Q9NX63, (Mouse) Q9CRB9
Entrez Gene ID: (Human) 54927, (Mouse) 66075